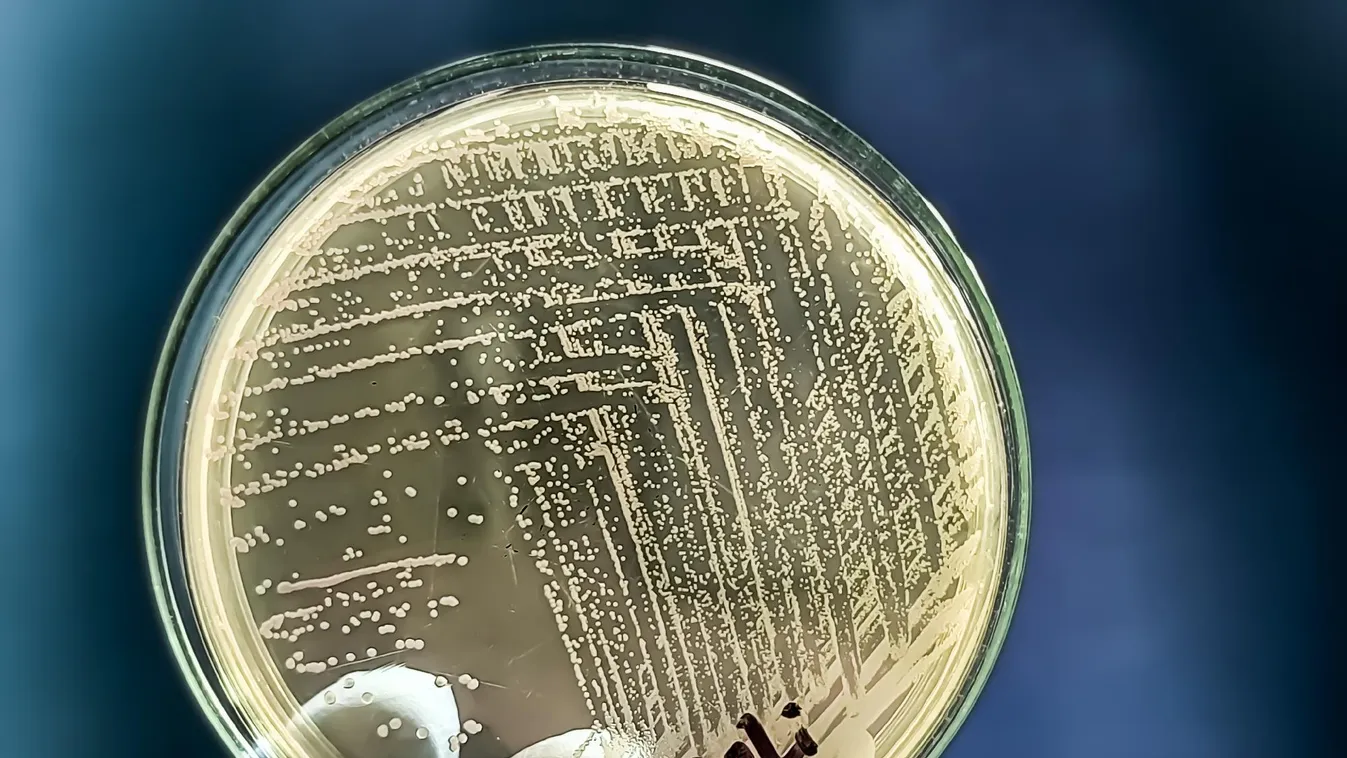
Szörnyű kór szedi áldozatait Belgiumban

A szövetségi élelmiszerlánc-biztonsági hivatal vizsgálatot indított a járvány forrásának azonosítására.
A fertőzötteket legalább nyolc flandriai idősotthonban azonosították, ahol hét haláleset történt, valamint egy vallóniai intézményben, ahol egy ember hunyt el. További megbetegedéseket jelentettek Brüsszelből és a vallóniai Ottignies-ből is. Jelenleg 63 beteg lakóról tudnak: 48-ról Flandriában, 14-ról Vallóniában és egyről Brüsszelben.
A STEC az E. coli baktérium egyik variánsa, amely lázat, fejfájást és heveny hasmenést okozhat. Súlyos esetben a fertőzés veseelégtelenséghez vezethet, főleg gyermekeknél és időseknél.
A flandriai esetek többségét a O157-es törzshöz köthető baktérium okozta. A vizsgálatok még tartanak annak megállapítására, hogy a vallóniai és brüsszeli fertőzések ugyanabból a forrásból származnak-e. A hatóságok szerint néhány héttel ezelőtt szennyezett élelmiszer kerülhetett forgalomba több idősotthonban. Bár újabb élelmiszerhez köthető megbetegedést nem azonosítottak, a tisztiorvosok arra figyelmeztetnek, hogy egyes friss esetek emberről emberre történő fertőzésből is eredhetnek.
A vizsgálat során szakemberek mintákat vesznek az érintett intézményekben, és ellenőrzik az élelmiszer-ellátási láncot, beleértve a közös beszállítókat is. A hatóságok szerint mivel a fertőzés már hetekkel ezelőtt elkezdődött, a nyomozás különösen bonyolult.
A helyi sajtó értesülései szerint valamennyi érintett otthon ugyanattól az élelmiszer-beszállítótól kapja az ellátmányt.
Fotó: Shutterstock